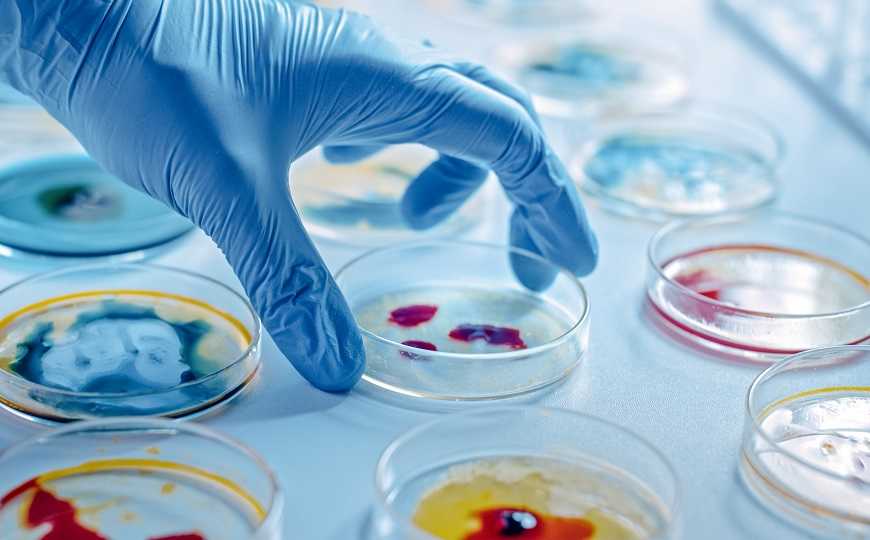

Биоинформатика открывает новый путь разработки антибиотиков
Исследователи из США проанализировали 10 000 сиквенсов бактериальных геномов и с помощью биоинформатического анализа спрогнозировали структуру антибиотика, который ранее не получали в лаборатории. Они создали липопептид, напоминающий этот антибиотик, и назвали его цилагицин. Новый препарат эффективно убивал грамположительные патогены in vitro, а после некоторых модификаций — также in vivo.
Распространение резистентности заставляет ученых искать все новые антибиотики. Многие бактерии способны к уничтожению других бактерий, но не все из них удается вырастить в лаборатории. И перенос антибактериальных генов в более «послушные» микроорганизмы тоже работает не всегда. Большая часть антибиотиков закодирована целыми кластерами генов биосинтеза, которые функционируют как единое целое, чтобы закодировать ряд белков. Такие кластеры часто остаются недоступными ученым.
Исследователи из США пошли другим путем. Они проанализировали геномные сиквенсы бактерий и с помощью специальных алгоритмов предсказали, какие антибиотики они бы могли производить. При этом абсолютная точность не требуется – задача состоит в том, чтобы получить молекулу, которая может действовать, как природное соединение. Особый интерес представляют нерибосомные липопептиды, так как многие подобные соединения подавляют рост бактерий.
Ученые проанализировали около 10 000 сиквенсов бактериальных геномов в поисках неохарактеризованных кластеров генов биосинтеза. Они сосредоточили внимание на кластере cil, анализ его предполагаемого продукта позволил получить два линейных липопептида и шесть циклических. Авторы проверили, насколько эффективно эти соединения справляются с грамположительными патогенами из группы ESKAPE (Enterococcus faecium, Staphylococcus aureus, Klebsiella pneumoniae, Acinetobacter baumannii, Pseudomonas aeruginosa и Enterobacter). Ученые выбрали самый удачный липопептид и назвали его «цилагицин».
Цилагицин был эффективен против всех протестированных грамположительных патогенов, в том числе антибиотикорезистентных, а также ванкомицин-резистентных энтерококков и Clostridioides difficile. Цилагицин также протестировали против панели из 19 штаммов S. aureus с различными паттернами резистентности к клинически релевантным антибиотикам, а также 30 ванкомицин-резистентных клинических изолятов энтерококков. Новый антибиотик и тут продемонстрировал свою эффективность.
Против грамотрицательных патогенов цилагицин не был эффективен, за исключением A. baumannii. Вероятно, внешняя мембрана этих бактерий блокирует доступ к таргету антибиотика. Даже в самых высоких концентрациях цилагицин не вредил человеческим клеткам.
Цилагицин — бактерицид, он снижает число живых бактерий более, чем на четыре порядка через четыре часа. Ученые попытались получить мутантные бактерии, резистентные к антибиотику, с целью изучить механизм его действия, однако это им не удалось. Они предположили, что цилагицин таргетирует не белок, а малую молекулу.
По-видимому, цилагицин связывает две малые молекулы — C55-P и C55-PP. C55-P — это монофосфорилированный изопрен, который необходим для транспорта интермедиата для биосинтеза углеводородных полимеров клеточной стенки через клеточную мембрану. C55-PP — его дифосфорилированная форма. Таким образом, у цилагицина два таргета, что снижает вероятность развития резистентности, но не устраняет ее.
Новый антибиотик вводили мышам через внутрибрюшинную инъекцию. Авторы отметили высокую биодоступность препарата в плазме. Однако он не снижал бактериальную нагрузку в мышиной модели. Антибактериальная активность цилагицина снижалась и просто в присутствии сыворотки. Поэтому исследователи получили аналог соединения со сниженной способностью взаимодействовать с сывороткой, но со сходным бактерицидным действием. Аналог хорошо показал себя на мышиной модели против таких патогенов, как S. aureus и S. pyrogens.
По словам Шона Брэйди из Рокфеллеровского университета, одного из авторов исследования: «Это не просто крутая новая молекула, это валидация нового подхода к открытию препаратов. Это исследование — пример того, как вычислительная биология, генетическое секвенирование и синтетическая химия совместно помогают разгадать загадки эволюции бактерий».
Источник
Wang Z., et al. Bioinformatic prospecting and synthesis of a bifunctional lipopeptide antibiotic that evades resistance // Science, 376, 6596, pp.991-996, published May 26, 2022, DOI: 10.1126/science.abn4213
Цитата по пресс-релизу


 Меню
Меню





 Все темы
Все темы




 0
0












